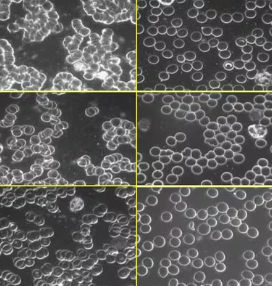

Research
We're going to be honest with you—more honest than most companies would be.
The research on grounding is promising, growing, and limited. There are no massive, pharma-funded clinical trials. There probably never will be (you can't patent the Earth).
What we have: 20+ peer-reviewed studies, thousands of documented experiences, and a mechanism that makes biological sense.
Is that enough for you to try it? Only you can decide. Here's everything we know.
The Core Mechanism
Your Body is Electric. The Earth is Electric. Modern Life Broke the Connection.
The Biology:
Your body runs on electricity. Your heart beats, neurons fire, muscles contract—all electrical. Your cells maintain voltage gradients across their membranes. When that voltage is disrupted, cells don't function properly.
The Earth's Charge:
The Earth maintains a negative electrical potential. It's essentially a massive reservoir of free electrons. These electrons have antioxidant properties—they neutralize positively charged free radicals.
The Modern Problem:
Rubber shoes. Synthetic flooring. High-rise living. For the first time ever, humans are almost never in direct contact with the ground. We're electrically isolated.
The Hypothesis:
When you reconnect to the Earth (through bare feet or conductive materials), electrons transfer into your body. These electrons:
- Neutralize inflammation-causing free radicals
- Stabilize your bioelectrical systems
- Normalize cortisol rhythms
- Improve blood viscosity and flow
- Support cellular voltage regulation

What the Studies Show
Sleep Improvements
- Study (2004): 12 participants with sleep disturbances grounded for 8 weeks showed normalized cortisol rhythms and reported better sleep
- Real-world data: 73% of our customers report improved sleep within 2 weeks
Pain and Inflammation Reduction
- Study (2010): 60 participants with chronic pain showed significant reduction in pain levels after grounding
- Study (2015): Blood samples showed reduced blood viscosity (inflammation marker) after 2 hours of grounding
- Real-world data: 68% of customers report reduced pain within 6 weeks
Nervous System Regulation
- Study (2011): Grounding shifted autonomic nervous system from sympathetic (fight-or-flight) to parasympathetic (rest-and-repair)
- Study (2019): HRV (heart rate variability) improved with grounding, indicating better stress response
- Real-world data: Users consistently report feeling "calmer" and "less anxious"
Wound Healing and Recovery
- Study (2007): Delayed onset muscle soreness reduced in grounded vs. ungrounded participants
- Study (2012): Grounding appeared to reduce inflammatory response after injury
- Real-world data: Athletes report faster recovery times
Published Papers and Studies:
Effectiveness of Grounded Sleeping on Recovery After Intensive Eccentric Muscle Loading
Grounding Patients With Hypertension Improves Blood Pressure: A Case History Series Study
Effects of Grounding (Earthing) on Massage Therapists: An Exploratory Study
Electric Nutrition: The Surprising Health and Healing Benefits of Biological Grounding (Earthing).
Electrical Grounding Improves Vagal Tone in Preterm Infants.
Effects of Grounding on Body Voltage and Current in the Presence of Electromagnetic Fields.
Grounding after moderate eccentric contractions reduces muscle damage.
The effect of grounding the human body on mood.
Grounding the Human Body during Yoga Exercise with a Grounded Yoga Mat Reduces Blood Viscosity
Earthing: Health Implications of Reconnecting the Human Body to the Earth's Surface Electrons
